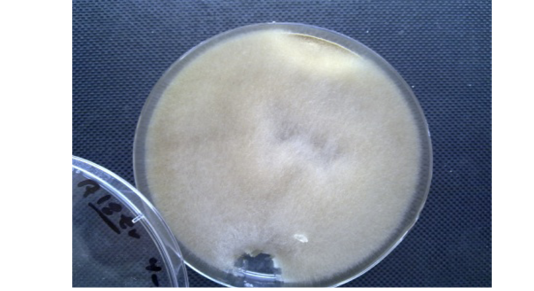

Advances in Animal and Veterinary Sciences
Absidia spp. macroscopically. Cottony in texture, Light Gray to creamy In color and the reverse side is uncolored or white.
Absidia spp. Microscopically. Nonseptate hyphae, funnel-shaped under sporangium, sporangiophore widens and round sporangiospores.(40X lens)
the liver of mouse at 48hr post infection shows, neutrophils () infiltration and fungal element surrounded by eosinopohilic substances (H&E stain 40X)
The liver at 72hr post infection shows amyloid ( ) like substance replacement hepatic cells with neutrophils in dilated sinusoids and central vein, fibrin ( ) deposition and aggregation of neutrophils ( ) in capsular region with fragment of hyphae (H&E stain20X)
kidney at 72hr post infection shows neutrophils ( ) around and in the lumen of BVs between renal tubules (H&EX)
The lung at 72hr post infection explained fibrin ( ), RBC and neutrophils ( ) in the alveolar space and lumen of BVs (H&Estain 40X)
Histopathological section in the liver of treated animal with β-glucan at 45day post infection shows mononuclear cells ( ) aggregation around central vein and kupffer cells prolifration (H&E stain 40X)
in the spleen of animal treated with β-glcan at 2 weeks post infection showes granulomatous lesion in adipose tissue of capsular region (H&E stain 40X)
the lung of animal treated with β-glucan at 45 day post infection shows mononuclear cells ( ) aggregation around congestion blood vessel (H&E stain 40X)